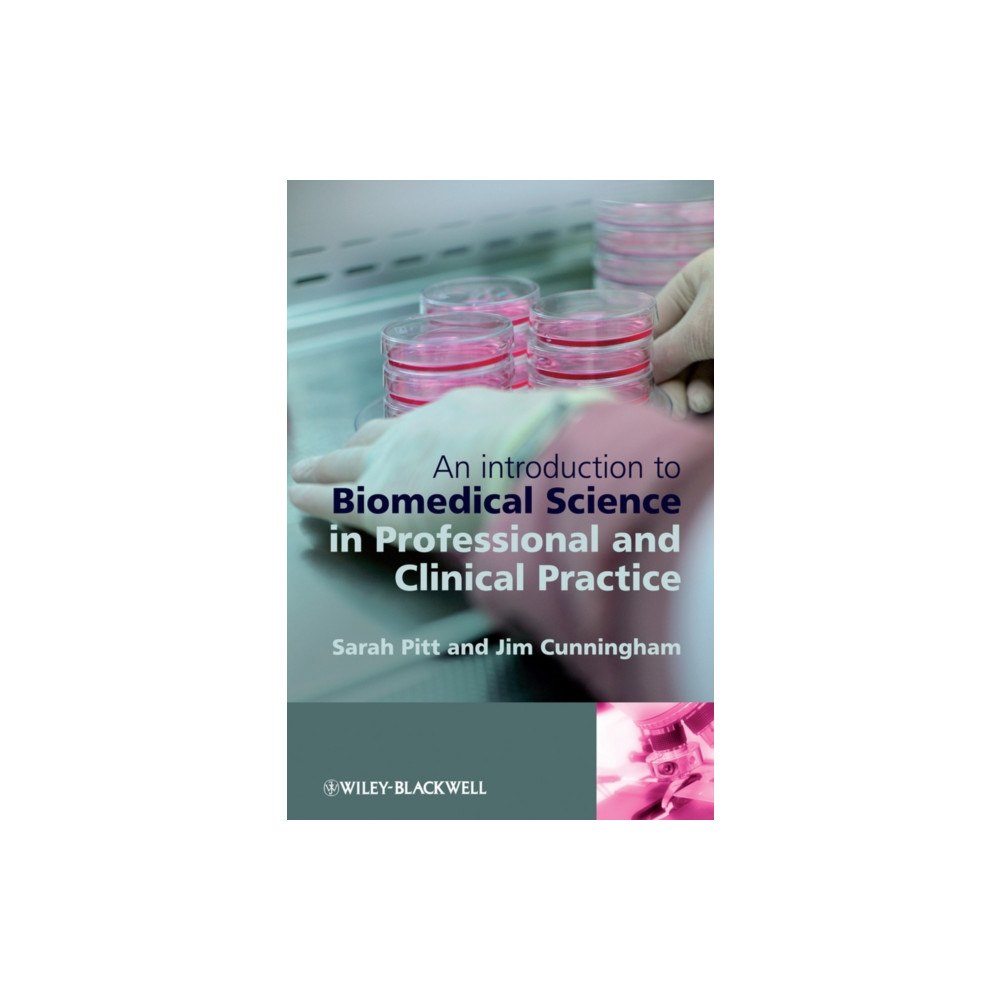
John Wiley & Sons Inc An Introduction to Biomedical Science in Professional and Clinical Practice (häftad, eng)

An Introduction to Biomedical Science in Professional and Clinical Practice (häftad, eng)
Biomedical Science in Professional and Clinical Practice is essential reading for all trainee biomedical scientists looking for an introduc...
688 kr
inkl. moms
Bara 2 kvar
Skickas inom 3 - 4 vardagar
EAN: 9780470057155
Specifikation
Det finns tyvärr inga specifikationer att visa för denna produkt.